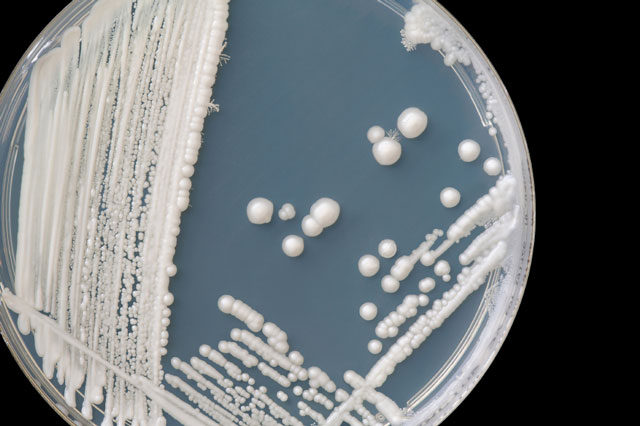
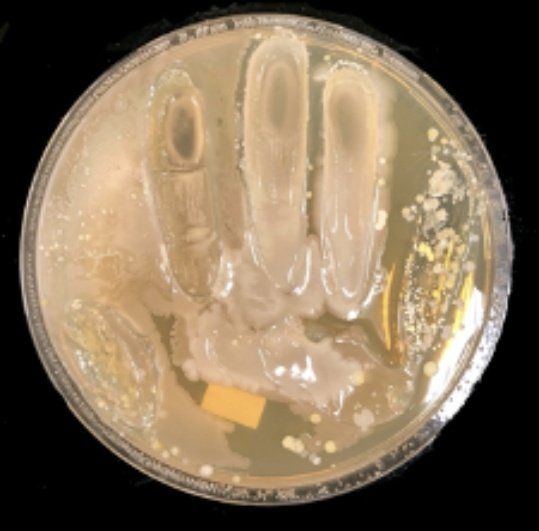

¡Qué famosos se volvieron los virus este año! 😷🤒😰Pero, ¿realmente los entendemos?
Esta semana, en mi curso de #Microbiología para todos, aprenderemos sobre los #virus. Usaremos como ejemplos a 3 de los más famosos: HPV (papiloma), influenza, y VIH. #MicroMondays 🤓🔬🧬 Hilo 👇🏾


Esta semana, en mi curso de #Microbiología para todos, aprenderemos sobre los #virus. Usaremos como ejemplos a 3 de los más famosos: HPV (papiloma), influenza, y VIH. #MicroMondays 🤓🔬🧬 Hilo 👇🏾



Para todo el desmadre que un virus ha causado este año, cuesta creer que los virus no están “vivos” vivos.
Un virus, por sí solo, no puede crecer ni multiplicarse ni fabricar nada. Un virus es como tener una caja de Lego, con las instrucciones pero sin ningún ladrillo.



Un virus, por sí solo, no puede crecer ni multiplicarse ni fabricar nada. Un virus es como tener una caja de Lego, con las instrucciones pero sin ningún ladrillo.




Me explico, un virus no es más que un trozo de material genético 🧬 (las instrucciones) protegido por una envoltura de proteína 📦 (la caja). Necesita invadir una célula y secuestrarla, usando sus partes (los Lego) para crear “bebés” virus según las instrucciones. 



Pero los virus son muy quisquillosos en cuanto a las células que pueden invadir y secuestrar. Cada virus tiene una “llave” que sólo abre un tipo de “puerta” en las células. La célula debe tener la puerta necesaria, o el virus no entra 🔐. 

Podemos entender una parte de la enfermedad causada por un virus viendo el tipo de célula que éste ataca. Por ejemplo, el VIH ataca unas células muy específicas del sistema inmune llamadas CD4. Al matar muchas CD4, deja muy débil al sistema inmune. 

Los virus son súper diversos. En esa variedad, hay virus capaces de hacer cosas realmente fascinantes (pero muy dañinas, si las vemos desde la perspectiva de un paciente). Veamos tres ejemplos de estos “trucos”.
Algunos virus pueden causar cáncer 😱. Nuestras células tienen un interruptor que controla y verifica su división. El HPV, o papilomavirus, daña este interruptor, y hace que las células se multipliquen sin control. Causa cáncer genital y de garganta. 





Algunos virus pueden transformarse 🙂🙃. Los virus de la influenza tienen su genoma dividido en 8 trozos. Si dos virus infectan la misma célula al mismo tiempo, pueden recombinar esas piezas y crear “bebés” completamente nuevos. Esto ha causado pandemias 😷. 





Algunos virus se demoran años en hacer daño ⌛️⏳⌛️⏳.
El VIH puede decidir no matar inmediatamente a las células que invade. En cambio, puede “integrarse” a su ADN y pasar desapercibido por años, eligiendo el momento perfecto para actuar.
El VIH puede decidir no matar inmediatamente a las células que invade. En cambio, puede “integrarse” a su ADN y pasar desapercibido por años, eligiendo el momento perfecto para actuar.

Cada uno de estos virus da para clases enteras. Lo que me importa que quede claro esta semana es que los virus:
1.Necesitan invadir células para multiplicarse.
2.Tienen estructuras comparativamente simples.
3.Son MUY diversos.
1.Necesitan invadir células para multiplicarse.
2.Tienen estructuras comparativamente simples.
3.Son MUY diversos.
Es súper difícil cultivar virus en el laboratorio. Por eso, las enfermedades virales se diagnostican principalmente con métodos genómicos (que miran el genoma del virus) o serológicos (que miran la respuesta inmune frente al virus). 



De seguro este tema traerá un montón de preguntas 🤨. Las espero con ansias.
Porfa, no se olviden de darle RT al primer tuit del hilo y contarle a sus amigos sobre esta iniciativa 🤓.
La próxima semana hablaremos sobre #parásitos.
Gracias por leerme 🥰
Porfa, no se olviden de darle RT al primer tuit del hilo y contarle a sus amigos sobre esta iniciativa 🤓.
La próxima semana hablaremos sobre #parásitos.
Gracias por leerme 🥰

• • •
Missing some Tweet in this thread? You can try to
force a refresh